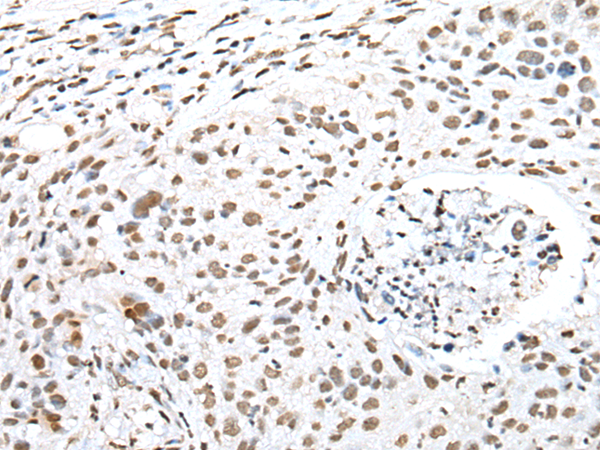

|
Background: |
The protein encoded by this gene associates with stem loop II of the U1 small nuclear ribonucleoprotein, which binds the 5' splice site of precursor mRNAs and is required for splicing. The encoded protein autoregulates itself by polyadenylation inhibition of its own pre-mRNA via dimerization and has been implicated in the coupling of splicing and polyadenylation. |
|
Applications: |
ELISA, WB, IHC |
|
Name of antibody: |
SNRPA |
|
Immunogen: |
Full length fusion protein |
|
Full name: |
small nuclear ribonucleoprotein polypeptide A |
|
Synonyms: |
U1A; Mud1; U1-A |
|
SwissProt: |
P09012 |
|
ELISA Recommended dilution: |
5000-10000 |
|
IHC positive control: |
Human lung cancer and human prostate cancer |
|
IHC Recommend dilution: |
25-100 |
|
WB Predicted band size: |
31 kDa |
|
WB Positive control: |
Human fetal liver tissue,A431 cell,293T cell,Hela cell , HEPG2 cell and A549 cell lysates |
|
WB Recommended dilution: |
500-2000 |

購物車
幫助
021-54845833/15800441009
